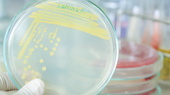
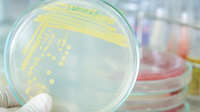

Wählen Sie den Vollbildmodus und öffnen Sie oben rechts ggf. den Lautsprecher!Ganz schön vielfältig!Ein Beitrag der Abteilung 2: Wirtschaft, Raumordnung, Bau-, Denkmal- und Gesundheitswesen
- Wählen Sie bitte den Vollbildmodus.
- Kontrollieren Sie oben rechts, ob der Lautsprecher eingeschaltet ist.
- Sie betrachten den Beitrag mit dem Handy? Dann halten Sie es am besten quer.
Was prägte das Jahr 2019? Wo sieht die Abteilung Wirtschaft, Raumordnung, Bau-, Denkmal- und Gesundheitswesen die Herausforderungen der Zukunft?Neue Aufgaben!
antwortet in der Audioaufnahme.
Sie hören nichts? Dann kontrollieren Sie oben rechts im Bild, ob der Lauptsprecher geöffnet ist.
Ganz schön vielfältig!
Ganz schön vielfältig!

So spielt sich die Auseinandersetzung um den denkmalgeschützten Eschersteg in Ravensburg überwiegend im Sachgebiet Denkmalschutz (Referat 21) ab, die Kolleginnen aus dem Bereich Gesundheitswesen und Arzneimittelüberwachung (Referat 25) haben damit gar nichts zu tun.
Aber schon die Städtebauförderung (Referat 22) ist im Boot und selbst die Planfeststellerinnen und Planfeststeller (Referat 24) sind beim Thema Eschersteg dabei – handelt sich dabei doch um eine Fußgängerüberführung über die Gleise der zu elektrifizierende Südbahn. Dies ist nur ein Beispiel dafür, wie wir die verschiedensten Aufgaben bündeln und im Zusammenwirken Lösungen entwickeln.
Geradezu eine Mammutaufgabe in Punkto Bündelung leisten auch die Regionalverbände bei der Gesamtfortschreibung der Regionalpläne für die Regionen Bodensee-Oberschwaben und Donau-Iller, die beide 2019 gestartet wurden. Hier hat Referat 21 (Sachgebiet Raumordnung) die Stellungnahmen im Haus koordiniert.
Weil die Regionalpläne wichtige Grundlage für die Steuerung der Flächennutzung sind, kommt es durchaus darauf an, wie sich das Regierungspräsidium zu den Planentwürfen positioniert. Sind die Flächenbedarfe für Gewerbe und Wohnen schlüssig begründet? Werden die naturschutzfachlichen und -rechtlichen Vorgaben richtig umgesetzt? Sind die Belange der Landwirtschaft ausreichend berücksichtigt? Bleibt genügend Raum für Anlagen der Erneuerbaren Energien? Werden Flächen für den Rohstoffabbau im richtigen Maß festgelegt? Zu all diesen Fragestellungen leistet das Regierungspräsidium mit seinen Abteilungen wichtige Beiträge, um zum Schluss eine gut abgewogene Regionalplanung für die nächsten 20 Jahre zu haben.
Ganz schön vielfältig
Ganz schön vielfältig

Vernetzung und Zukunftssicherung sind Stichworte, bei denen zwangsläufig die Tätigkeit des Kompetenzzentrums Energie in den Blick gerät.
Die Unterstützung der regionalen Photovoltaiknetzwerke war und ist ein Schwerpunktthema des KZE, um damit den Ausbau erneuerbarer Energien voranzubringen. Auch hier ist es unsere Aufgabe, im Widerstreit verschiedener öffentlicher und privater Belange sachliche Grundlagen zu schaffen, zu vermitteln und zur Lösungsfindung beizutragen. Beispiele für konkrete Tätigkeiten konkreter Menschen finden Sie in den Einzelberichten.
Weitere Beiträge aus den Abteilungen
Agil arbeiten!
Ein Beitrag der Abteilung 1:
Steuerung, Verwaltung und Bevölkerungsschutz
Den Ländlichen Raum nachhaltig entwickeln
Ein Beitrag der Abteilung 3:
Landwirtschaft, Ländlicher Raum, Veterinär- und Lebensmittelwesen
Dialogorientierte Straßenplanung am Bodensee
Ein Beitrag der Abteilung 4: Straßenwesen und Verkehr
Die Umwelt im Blick
Ein Beitrag der Abteilung 5:
Umwelt
Schule schafft Zukunft!
Ein Beitrag der Abteilung 7:
Schule und Bildung
Virtuell planen - real bauen: mit dem Building Information Modeling (BIM)
Ein Beitrag der Abteilung 9: Landesstelle für Straßentechnik
Vision und Mission 2020+
Ein Beitrag der Abteilung 10:
Eich- und Beschusswesen
Das bundesweite Netz der Marktüberwachung
Ein Beitrag der Abteilung 11: Marktüberwachung
Nachweise
Nachweise
Multimediale Projektwebsite mit Beiträgen der Abteilungen des Regierungspräsidiums Tübingen.

Konzeption und Gestaltung: Silvia Langer (Koordinierungs- und Pressestelle) und Susanne Eißler (Referat 11 – Organisation, Information und Kommunikation)
Fotocredits: Regierungspräsidium Tübingen, soweit im Bild nicht anders ausgewiesen.
- Bild zum Wohle der Patienten/Laborforschung.
©
Motortion-stock.adobe.com
- Bild Petrischale mit Kultur: © thitiya-stock.adobe.com
- Bild Überwachung von Arzneimitteln: © Angela_rohde-stock.adobe.com
- Bild Freiflächensolaranlage: © Simon_kraus-stock.adobe.com
- Bild: In die Gesundheit investieren/Telemedizin: ©tippapatt-stock.adobe.com
- Bild: Inspektionen zu innovativen biotechnologischen Arzneimitteln/Immuntherape: © Рита Пирогова-stock.adobe.com
- Bild zu Überwachung von Medizinprodikten: © io-stock.adobe.com
- Bild Telemedizin - in die Gesundheit investieren:
©tippapatt-stock.adobe.com
- Vernetzung: © esoxx-stock.adobe.com
- Metall-Gliederketten: © Laroslav_Neliubov-stock.adobe.com
- Klassenzimmer. © Dmitry_Vereshchagin-stock.adobe.com
- Luftbild Bodensee: © Gerhard Plessing Flug und Bild
Impressum
Regierungspräsidium Tübingen Pressestelle
Konrad-Adenauer-Straße 20
72072 Tübingen
Pressestelle: 07071 757-3005
Zentrale: 07071 757-0
07071 757-3190 V.i.S.d.P:
Pressesprecher Dirk Abel
Hinweis: Die Informationen, die Sie auf dieser Website vorfinden, wurden nach bestem Wissen und Gewissen sorgfältig zusammengestellt und geprüft. Es wird jedoch keine Gewähr - weder ausdrücklich noch stillschweigend - für die Vollständigkeit, Richtigkeit, Aktualität oder Qualität und jederzeitige Verfügbarkeit der bereit gestellten Informationen übernommen. In keinem Fall wird für Schäden, die sich aus der Verwendung der abgerufenen Informationen ergeben, eine Haftung übernommen. Diese Website enthält auch Links oder Verweise auf Websites Dritter. Diese Links zu den Websites Dritter stellen keine Zustimmung zu deren Inhalten durch den Herausgeber dar. Es wird keine Verantwortung für die Verfügbarkeit oder den Inhalt solcher Websites übernommen und keine Haftung für Schäden oder Verletzungen, die aus der Nutzung - gleich welcher Art - solcher Inhalte entstehen. Mit den Links zu anderen Websites ermöglichen die Regierungspräsidien den Nutzern lediglich den Zugang zur Nutzung der Inhalte. Für illegale, fehlerhafte oder unvollständige Inhalte und für Schäden, die aus der Nutzung entstehen, haftet allein der Anbieter der Seite, auf welche verwiesen wurde.
Datenschutz
© 2020 Regierungspräsidium Tübingen
Wir danken allen Autorinnen und Autoren für Ihre Beiträge!

In die Gesundheit investieren
In die Gesundheit investieren

Innerhalb der Krankenhausfinanzierung beispielsweise, wurden im vergangenen Pauschalfördermittel an 30 Plankrankenhäuser in Höhe von rd. 18,3 Mio. Euro bewilligt. Erstmalig beinhaltete der Betrag auch rund 1,17 Millionen Euro aus Mitteln des „Sonderprogramms Digitalisierung“ des Landes, um die Krankenhäuser des Regierungsbezirks auf ihrem Weg in eine digitale Zukunft zu unterstützten.
Für eine gute Krankenhausversorgung ist die sogenannte Mensch-zu-Mensch-Kommunikation unerlässlich. Dennoch müssen Krankenhäuser auch die Weiterentwicklung in Richtung eines digitalen und vernetzten Krankenhauses der Zukunft vorantreiben und in moderne Ausstattung und Technik investieren.
Die Pauschalfördermittel, die zweckbestimmt für die Erneuerung der Einrichtungs- und Ausstattungsgegenstände eingesetzt werden müssen, leisten einen Beitrag zur Modernisierung der medizinisch-technischen Ausstattung, zur Verbesserung der IT-Ausstattung und IT-Sicherheit und ebnen den Weg hin zu einer digitalen Infrastruktur. Dies ist dringend erforderlich zur Optimierung der Arbeitsabläufe und Prozesse, aber auch für die sektorenübergreifende Kommunikation und für telemedizinische Anwendungen der Zukunft.Foto: ©tippapatt-stock.adobe.com
Bibliotheken für morgen!
Bibliotheken für morgen!

Im Regierungsbezirk wurden Bibliotheken ausgezeichnet.

Das von der Hochschule der Medien in Stuttgart ausgerufene Projekt hat zum Ziel, Bibliotheken als Leuchtturmprojekte auszuzeichnen, die sich durch professionelles Qualitätsmanagement über Jahre weiterentwickeln. Die Gemeindebücherei Dettingen, die Stadtbibliothek Sigmaringen sowie der Treffpunkt Bücherei Uhldingen – Mühlhofen konnten eine Jury von ihrer besonders hohen und nachhaltigen Qualität im Bereich „Zukunfts- und Kundenorientierung“, Verbesserungsprozesse, Strategie, Arbeitsabläufe und -ergebnisse überzeugen. Bei der Durchführung des Projekts wurden die drei Bibliotheken umfänglich von den Mitarbeiterinnen und Mitarbeitern der Bibliotheksfachstelle des Regierungspräsidiums begleitet.
Diese beraten die öffentlichen Bibliotheken des Regierungsbezirks bei ihrer täglichen Arbeit kompetent u.a. hinsichtlich Ressourcenmanagement, Bibliotheks(um)bau, Medienausstattung und Personaleinsatz. Der Festakt und die Ausführungen der Preisträger machten wiederum deutlich, welche zentrale Rolle Bibliotheken insbesondere im Ländlichen Raum als „dritter Ort“, als vernetzende Kommunikationsplattform und als Bildungsressource heute schon einnehmen und erst Recht in der Zukunft spielen werden

Preisrecht...rechnet sich! Schlauer in 60 Sekunden! Karin Bachleitner erklärt die Aufgaben der Preisprüfung. Drücken Sie unten links auf das Audio-Symbol und prüfen Sie, ob der Lautsprecher angestellt ist.
Das Sachgebiet Preisüberwachung des Referats 22 hat im Jahr 2019 weit mehr als hundert Preis- und Kostenprüfungen durchgeführt.
Bei 42 Prüfungen konnten Rechnungskürzungen im Wert von über 450.000 Euro realisiert werden. Im Rahmen der Amtshilfe für die Projektträger des Bundesforschungs- und des Bundeswirtschaftsministeriums wurden auch wieder zahlreiche interessante öffentlich geförderte Forschungsprojekte geprüft.Besonders interessant war die Prüfung des vom Forschungszentrum Jülich geförderten Projekts „Entwicklung und Optimierung eines Antriebsstrangs für Gezeitenströmungsturbinen“ bei der Firma ANDRITZ Hydro in Ravensburg.
Die Firma ANDRITZ Hydro hat eine Gezeitenströmungsturbine entwickelt und auf dem Meeresgrund vor der Küste Schottlands installiert. Die Unterwasser-Propeller werden von den Gezeitenströmungen angetrieben und wandeln die Energie aus dem Tidenhub des Meeres in elektrischen Strom um.
Das erfolgreich abgeschlossene Projekt lieferte viele Erkenntnisse über die Erzeugung von sauberer, erneuerbarer und nachhaltiger Energie. Der Vorteil von Wasserkraft und Meeresenergie gegenüber der Windenergie besteht darin, dass die Energie zeitlich recht konstant bereitgestellt werden kann. Inzwischen ist das größte geplante Gezeitenkraftwerk in Schottlands unwirtlichem Pentland Firth im Bau.
Die Preisüberwachungsstelle stellt durch zeitnahe Kostenprüfungen sicher, dass auch weiterhin Fördergelder für interessante Forschungsprojekte in den Regierungsbezirk Tübingen fließen. Denn bei der Vergabe von Fördergeldern ist es für das Bundesforschungs- und das Bundeswirtschafts-ministerium wichtig, dass eine zeitnahe Überprüfung der sachgerechten Verwendung der öffentlichen Gelder erfolgt.
Foto: © ANDRITZ Hydro, Hammerfest
Landesstelle für Bautechnik
Innovative Bauprodukte
Als Grundlage für die Ermittlung von Rechenwerten für Baustoffe bedarf es zunächst, im direkten Kontakt mit einer anerkannten Materialprüfstelle, der Erarbeitung von Vorgaben für erforderliche Versuche. Die statistische Auswertung der Versuchsergebnisse muss das für Bauwerke maßgebende Sicherheitsniveau gewährleisten. Im Folgenden werden vier solcher Projekte vorgestellt.
Bundesgartenschau Heilbronn 2019Leichtbau-Pavillons mit internationaler Aufmerksamkeit!
Weil man sich mit den Projekten sehr weit in die Zukunft des Bauens wagte, fanden die für die Bundesgartenschau in Heilbronn vom Institut für Computerbasiertes Entwerfen und Baufertigung (ICD) und vom Institut für Tragkonstruktionen und Konstruktives Entwerfen (ITKE) der Universität Stuttgart entwickelten Leichtbau-Pavillons in der Fachwelt internati-onale Beachtung.
Für die stützenlose Überdachung der zentralen Konzert- und Veranstaltungsflächen wurden die Tragwerke in Anlehnung an biologische Tragstrukturen der Natur umgesetzt. Diese Übertragung von evolutionär optimierten Strukturen auf technische Konstruktionen wird als Bionik bezeichnet.
Im Vergleich zu massiven Holzelementen ist es mit dieser Bauweise zwar möglich, Materialaufwand und einhergehend Gewicht deutlich zu reduzieren, allerdings ergibt sich wegen der großen Anzahl unterschiedlicher Bauteile eine viel aufwändigere Fertigung. Entwurf, statische Berechnung und Fertigung sind somit nur programmgesteuert möglich.
Zusammengesetzt wurde die Schale, unter der 300 Personen Platz finden, wie ein dreidimensionales Puzzle ohne Unterkonstruktionen oder Stützgerüste. Die Landesstelle für Bautechnik hat die Tragsicherheit der vom Roboter ausgeführten Leimung der Holzelemente bewertet.
Elytra als Vorbild
An der höchsten Stelle ist das Bauwerk sieben Meter hoch. Regendicht wird das Bauwerk durch eine, mit Stahlseilen ge-spannte 0,3 Millimeter dünne Kunststofffolie. Die Wandungen der Röhren bestehen aus, in Harz getränkten hellen Glas- und dunklen Kohlefasern. Für die Herstellung der Röhren wurden von Robotern wieder und wieder die „unendlich langen“ Fasern um feste Ankerpunkte von einem Röhrenende zum anderen gewickelt. So entstanden insgesamt 60, drei bis fünf Meter lange Elemente und sieben verschiedene Typen. Weil ein Element zwischen 60 und 80 Kilogramm schwer ist, wiegt die Gesamtkonstruktion lediglich drei Tonnen.
Ausgehend von Erkenntnissen an Bauteilversuchen an Einzelelementen hat die Landesstelle für Bautechnik die Tragsicherheit und die Stabilität der Gesamtkonstruktion bewertet.
Carbonbeton im Brückenbau
Carbonbeton im Brückenbau


In den Stellungnahmen der Landesstelle für Bautechnik für die Brücken aus sogenanntem „Carbonbeton“ der Stadt Albstadt wird auf der Grundlage von Tragversuchen des Instituts für Massivbau der RWTH Aachen die ausreichende Standsicherheit, Gebrauchstauglichkeit und Dauerhaftigkeit bestätigt. Dieser neuartige Carbonbeton der solidian GmbH aus Albstadt wurde für die Realisierung von, auf Stahlträgern aufliegenden Fahrbahnplatten für zwei kommunale Straßenbrücken (Spannweiten 6,50 m bzw. 11 m) sowie für eine Fußgänger- und Radwegbrücke (Spannweite 15m) verwendet. Zur Sicherstellung der ausreichenden Tragfähigkeit des Carbonbetons, wurde an Stelle von Betonstahlmatten ein gitterförmiges epoxidharzgetränktes Textilgelege aus Carbonfasern (auch Kohlenstofffasern genannt) mit einer Faserquerschnittsfläche von 3,6mm² und einem Achsabstand von 38mm in Beton eingegossen.
Vorteil Klimaschutz
Großer Vorteil dieser Bauweise ist die Reduzierung der Bauteildicke bei gleichbleibender Tragfähigkeit. Diese rührt daher, dass die Kohlenstofffasern nicht korrodieren und einhergehend die gegenüber Stahlstäben erforderliche Betondeckung zur Vermeidung einer Korrosion vermindert werden kann. Zur Gewichtsreduzierung trägt weiterhin ein hochfester Beton (C70/80) bei, so dass eine Ausführung der Bauteile als Fertigteil möglich wird und sich einhergehend die Bauzeit am Bauort reduziert. Die Fahrbahnplatten der Straßenbrücken konnten mit einer Dicke von 14 cm und die der Fußgängerbrücke mit einer Dicke von 9 cm (Stegdicke 7cm) hergestellt werden. Dies spart Material und Masse, reduziert damit den CO2-Ausstoß und trägt somit zum Klimaschutz bei.

Sicher rutschen in Rust Wasserrutschen im Europapark Rust
Sicher rutschen in Rust Wasserrutschen im Europapark Rust

Die einzelnen Segmente der Röhren bestehen aus glasfaserverstärktem Kunststoff (GFK). Die Röhren sind selbsttragend, d. h. sie müssen Lasten aus Eigengewicht, Wasser und Personen (einschließlich Fliehkräften) auf die sie unterstützenden Bauteile aus Stahl oder Beton übertragen. Für die Befestigung der Segmente untereinander sind, für die Anordnung von Schrauben, verdickte Flanschbereiche erforderlich.
Weil Rutschen teilweise entlang der Außenfassaden angeordnet sind, müssen bei der Bemessung zudem Schnee- und Windlasten und das temperaturabhängige Tragvermögen der Kunststoffbauteile berücksichtigt werden.
Damit die Sicherheit für die Besucherinnen und Besucher bei Nutzung der europaweit außergewöhnlichen Attraktionen gewährleistet ist, gibt es im Zustimmungsbescheid der Landesstelle Vorgaben, die vom Hersteller, dem Aufsteller der statischen Berechnung, dem Montagebetrieb aber auch vom Betreiber der Anlage (für wiederkehrende Inspektionen durch sachverständige Stellen) einzuhalten sind.
Kommunen nachhaltig entwickelnDie Städtebauförderung als wichtiges Infrastrukturprogramm
Dank eines breit angelegten und über den Zeitraum einer Förderperiode flexiblen Förderinstrumentariums können auf individuelle Bedürfnisse von Bürgerinnen und Bürgern eingegangen und mit geeigneten Maßnahmen gesamtheitliche Erfolge erzielt werden.
Nachhaltigkeit als oberstes Gebot
Nachhaltigkeit als oberstes Gebot

Wohnraum schaffen!
Der Erhalt und die Schaffung bedarfsgerechter, bezahlbarer Wohnangebote zur Unterstützung langfristig sozial- und altersgemischter Bewohnerstrukturen sowie intakter Stadtteile und eine prioritäre Innenentwicklung runden den Nachhaltigkeitsgedanken in diesem Bereich ab.
Fördervorlumen auf Rekordhöhe!
Fördervorlumen auf Rekordhöhe!

Unterstützt werden konnten im vergangenen Jahr beispielhaft wieder die Modernisierung von Gemeinbedarfseinrichtungen wie Kindergärten, Gemeindehäusern oder Bibliotheken, die Schaffung von Aufenthaltsbereichen und innerörtlicher Erschließung und die Reaktivierung von Brachflächen.
Es bleiben aber auch in den kommenden Jahren noch zahlreiche Aufgaben für nachhaltige Investitionen im Bereich der Städtebauförderung. Die aktuellen Entwicklungen im Zusammenhang mit der Corona-Pandemie werden zu neuen gesellschaftlichen Aufgaben führen, für deren Lösung die Städtebauförderung ein verlässlicher und wichtiger Partner bleiben wird.
Überwachung von Medizinprodukten
Das Regierungspräsidium steht im Fokus vieler Anfragen betroffener Hersteller, die in der Umstellungszeit verunsichert waren. Dabei geht es im Wesentlichen um die Verlängerung der Gültigkeit von Zertifikaten bei Verlust der Benannten Stelle, die keine Benennung nach den neuen Regelungen erhält sowie um Fragen zur klinischen Bewertung der Medizinprodukte, an die künftig strengere Anforderungen gestellt wird. Zu Gesetzentwürfen müssen zeitnah Stellungnahmen geliefert werden und zahlreiche praktische Fragestellungen bedürfen der Abstimmung mit anderen Behörden.
Auch im Bereich der Überwachung der Aufbereitung mehrfach verwendbarer Medizinprodukte ergaben sich 2019 – wie in den Vorjahren – zahlreiche Aspekte der Vernetzung. Dabei hat der Kontakt zu Ärzten aller Fachrichtungen ein einheitliches und wichtiges Ziel in Bezug auf die Anwendung sicherer Medizinprodukte: Hier wird der Anwender geschützt und natürlich auch die Patientensicherheit sichergestellt.So kontrollieren wir z. B. schwerpunktmäßig Zahnarztpraxen, wo viele Medizinprodukte nach Verwendung für den erneuten Einsatz aufbereitet (gereinigt, desinfiziert, sterilisiert) werden.
Foto: © io-stock-adobe.com
Inspektionen zu innovativen biotechnologischen Arzneimitteln
Therapieverbessernde Innovationen gibt es durchaus auch bei klassischen Darreichungsformen der Arzneimittel – genannt sei die Entwicklung spezieller Überzüge für Kapseln oder Tabletten zur Steuerung von Ort und Zeitpunkt der Wirkstoffabgabe.
Zu den besonders innovativen Themen der landesweit für Fragen der Arzneimittel- und Wirkstoffherstellung zuständigen Leitstelle Arzneimittelüberwachung Baden-Württemberg zählten 2019 insbesondere die genetische Immuntherapie bösartiger Blutkrebsformen mit CAR-T-Zellen. Hier gilt es, ganz aktuelle wissenschaftliche Entwicklungen und oft der rasanten Entwicklung hinterherhinkende arzneimittelrechtliche Vorgaben in Abstimmung mit den für die Zulassung zuständigen Bundesbehörden in Einklang zu bringen.
Im Jahr 2019 wurden bei vielen Pharmafirmen produktbezogene Inspektionen zu innovativen biotechnologischen Arzneimitteln durchgeführt. Im Fokus stehen hier sowohl klassische gentechnologisch produzierte Biopharmazeutika , zum Beispiel so genannte monoklonale Antikörper oder Proteine, als auch Arzneimittel für neuartige Therapien - so genannte ATMP, Advanced Therapy Medicinal Products.
Hier gilt es die Inspektionen samt Erweiterung der bestehenden Erlaubnisse zusammen mit den Bundesoberbehörden (Zulassungsbehörden) erfolgreich zu gestalten. Es müssen die zulassungsrelevanten Fragen geklärt, die ausreichende Übereinstimmung der Herstellungsabläufe mit den bestehenden Regularien herbeigeführt und schließlich die regulatorisch notwendigen Dokumente (Herstellungserlaubnis, GMP-Zertifikate) ausgestellt werden. Dies konnte 2019 in fast allen Fällen erreicht werden.
Foto: © Рита Пирогова-stock.adobe.com
Zum Wohle der Patienten!
Die Photovoltaik-Netzwerke im Regierungsbezirk Tübingen Sonnige Aussichten für Solarprojekte
Ein wichtiger Teil der Solaroffensive Baden-Württemberg ist der Abbau von Barrieren bei der Errichtung von Photovoltaikanlagen durch regionale Netzwerke in den 12 Regionen des Landes und einer landesweiten Koordination. Ansprechpartner des Photovoltaiknetzwerks in der Region Neckar-Alb sind die Energie- und Klimaschutzagenturen der Landkreise, in der Region Bodensee-Oberschwaben, die Energieagentur Ravensburg und in der Region Donau-Iller, der unw e.V. (Ulmer Initiativkreis nachhaltiger Wirtschaftsentwicklung).
Als einer von vielen Akteuren aus zahlreichen Bereichen unserer Gesellschaft bringt sich auch das Kompetenzzentrum Energie am Regierungspräsidium Tübingen in die Netzwerke ein und profitiert umgekehrt von den Informationen und Kenntnissen der anderen Akteure bei seiner Beratungstätigkeit.
Zu den regionalen Photovoltaik-Netzwerken entwickelte sich aus den bereits Ende 2018 vom Kompetenzzentrum Energie initiierten Kennenlerngesprächen im Jahr 2019 eine enge Zusammenarbeit mit jedem der drei regionalen Netzwerke im Bezirk. Vor allem bei der Beratungstätigkeit des Kompetenzzentrums Energie zu einzelnen Photovoltaikvorhaben zeigt diese Zusammenarbeit bereits positive Wirkung: Die Netzwerke bringen ihre Kenntnisse rundum die Energieberatung sowie die regionale Verwurzelung ein.
Foto: © SimonKraus-stock.adobe.com
"Energiedialog on tour"
"Energiedialog on tour"

Unter der Überschrift „Solare Energien und Energieeffizienz, praktisch erlebbar“ wurden am 06.11.2019 im Ulmer Stadthaus die Projekte der Solarstiftung des unw e.V. (Ulmer Initiativkreis nachhaltige Wirtschaftsentwicklung e.V.) präsentiert und darüber hinaus aktuelle solare Themen in Vorträgen vorgestellt und diskutiert. Das Kompetenzzentrum Energie hat bei der Veranstaltung über „Photovoltaik-Freiflächenanlagen“ informiert. Außerdem wurde die Veranstaltung „Kommunaler Klimaschutz“ im Landkreis Reutlingen vorbereitet, zu der das Kompetenzzentrum Energie am 21.01.2020 mit einem Vortrag über Freiflächen-Photovoltaikanlagen beitrug. Die Zusammenarbeit des Kompetenzzentrums Energie und der Photovoltaik-Netzwerke soll auch im Jahr 2020 fortgesetzt und vertieft werden. Gemeinsame Aktionen sind insbesondere im Zusammenhang mit dem seitens des Umweltministeriums veröffentlichten „Handlungsleitfaden Freiflächensolaranlagen“ geplant.
Die Pflegeausbildung wurde generalisiert
Die Pflegeausbildung wurde generalisiert

Für die hochschulische Pflegeausbildung wird das Regierungspräsidium Tübingen Vor-Ort-Präsidium
Die Schulen und Träger der praktischen Ausbildung aus verschiedensten Versorgungsbereichen haben neue Kooperationen geschlossen und neue Modelle des Miteinanders entwickelt, um die Ausbildung auf eine solide Basis zu stellen. So sind auch im Haus die betroffenen Referate 23, 25 und 76 den Weg zur Etablierung der neuen Ausbildung gemeinsam gegangen und haben 2019 die erste gemeinsame Besprechung der Gesundheits- und (Kinder-) Krankenpflege- und Altenpflegeschulen durchgeführt.
In den Landkreisen wurden Koordinierende eingestellt, die über Landkreisgrenzen hinweg und gemeinsam mit dem Regierungspräsidium ausreichend praktische Ausbildungseinsätze für unsere neuen Pflegeauszubildenden generieren. Die Zulassung geeigneter Einrichtungen wird zentral von Referat 25 wahrgenommen, die Kolleginnen und Kollegen haben gemeinsam die erforderlichen Antragsformulare entwickelt.
Für die ebenfalls beginnende neue hochschulische Pflegeausbildung wird das Regierungspräsidium Tübingen als Vor-Ort-Präsidium zuständig sein. Sowohl die neue Ausbildung als auch die hochschulische Ausbildung sind in Referat 25 angesiedelt, für die öffentlichen Schulen bleibt die Zuständigkeit bei Referat 76.
Überwachung und Zulassung mikrobiologischer Labore
Aufgrund der inhaltlichen Überschneidungen wurde ihm im Dezember 2017 zudem die Zuständigkeit für Labore und Einrichtungen übertragen, die der Erlaubnispflicht gemäß § 15 Biostoffverordnung unterliegen.
Das Spektrum an Laboren reicht von kleinen Ein-Personen-Laboren in den Bereichen Umwelt- oder Wasseranalytik, über Labore der niedergelassenen Ärzte und Tierärzte, Qualitätskontroll-und Forschungslabore in der Lebensmittel-, Pharma- oder Medizinprodukteindustrie, universitären und privaten Forschungslaboren hin zu großen privaten, klinikeigenen oder universitären Diagnostiklaboren. Im Bereich der Biostoffverordnung kommen noch die Einrichtungen des Gesundheitsdienstes hinzu, die für Tätigkeiten der Schutzstufe 4 vorgesehen sind, sogenannte Sonderisolierstationen, in denen Patienten versorgt werden, die beispielsweise an Ebola erkrankt sind.
Insgesamt wurden 180 vor Ort Laborinspektionen durchgeführt. Dies waren teilweise Erstinspektionen oder Inspektionen aufgrund von Umbauten oder Änderungen, größtenteils aber Routineinspektionen. Das gewöhnliche Inspektionsintervall für angezeigte Labore liegt bei 2-3 Jahren. Die 21 Labore der Schutzstufe 3 werden nach Möglichkeit jedes Jahr inspiziert. Für Labore, die über die Jahre hinweg selten Mängel aufwiesen oder bei denen aufgrund des Untersuchungsspektrums und der Untersuchungsmethoden nur von einer sehr geringen potentiellen Gefahr ausgegangen werden kann, werden auch größere Intervalle festgelegt.Gravierende Mängel, die zu einer Untersagung der Tätigkeiten geführt hätten, wurden 2019 nicht festgestellt, was auch das Ergebnis der regelmäßigen Überwachung ist.
Neben den Regelüberwachungen und Zulassungen stehen die Inspektoren den Laboren auch beratend zur Seite, wenn es darum geht, Labore um- oder neu zu bauen. Die Begleitung in der Planungs- und Bauphase wird von den Laborbetreibern sehr geschätzt und hat sich auch für die Überwachungsbehörde außerordentlich bewährt, da gravierende Probleme im Zulassungs- und Überwachungsverfahren so können vermieden werden können.
Foto: © thitiya-stock.adobe.com
Überwachung von Arzneimitteln
Nach verschiedenen Vorfällen aufgrund von – medial verbreiteten – Skandalen in anderen Gebieten Deutschlands (Todesfälle durch von Heilpraktikern gemixte Arzneicocktails, Todesfälle durch von Ärzten hergestellte unsterile Injektionen) soll in Baden-Württemberg eine systematische und risikobasierte Überwachung etabliert werden.
Foto: © AngelaRohde-stock.adobe.com

Ganz schön vielfältig!
Ganz schön vielfältig!
 Neue Aufgaben!
Neue Aufgaben!
 Ganz schön vielfältig!
Ganz schön vielfältig!
 Ganz schön vielfältig
Ganz schön vielfältig
 Klicken Sie auf die Fotos!
Klicken Sie auf die Fotos!
 Weitere Beiträge aus den Abteilungen
Weitere Beiträge aus den Abteilungen
 In die Gesundheit investieren
In die Gesundheit investieren
 Bibliotheken für morgen!
Bibliotheken für morgen!
 Preisrecht...rechnet sich!
Preisrecht...rechnet sich!
 Innovative Bauprodukte
Innovative Bauprodukte
 Leichtbau-Pavillons mit internationaler Aufmerksamkeit!
Leichtbau-Pavillons mit internationaler Aufmerksamkeit!
 Carbonbeton im Brückenbau
Carbonbeton im Brückenbau
 Sicher rutschen in Rust
Sicher rutschen in Rust
 Kommunen nachhaltig entwickeln
Kommunen nachhaltig entwickeln
 Nachhaltigkeit als oberstes Gebot
Nachhaltigkeit als oberstes Gebot
 Wohnraum schaffen!
Wohnraum schaffen!
 Fördervorlumen auf Rekordhöhe!
Fördervorlumen auf Rekordhöhe!
 Überwachung von Medizinprodukten
Überwachung von Medizinprodukten
 Inspektionen zu innovativen biotechnologischen Arzneimitteln
Inspektionen zu innovativen biotechnologischen Arzneimitteln
 Zum Wohle der Patienten!
Zum Wohle der Patienten!
 Sonnige Aussichten für Solarprojekte
Sonnige Aussichten für Solarprojekte
 "Energiedialog on tour"
"Energiedialog on tour"
 Die Pflegeausbildung wurde generalisiert
Die Pflegeausbildung wurde generalisiert
 Überwachung und Zulassung mikrobiologischer Labore
Überwachung und Zulassung mikrobiologischer Labore
Überwachung von Arzneimitteln
Überwachung von Arzneimitteln